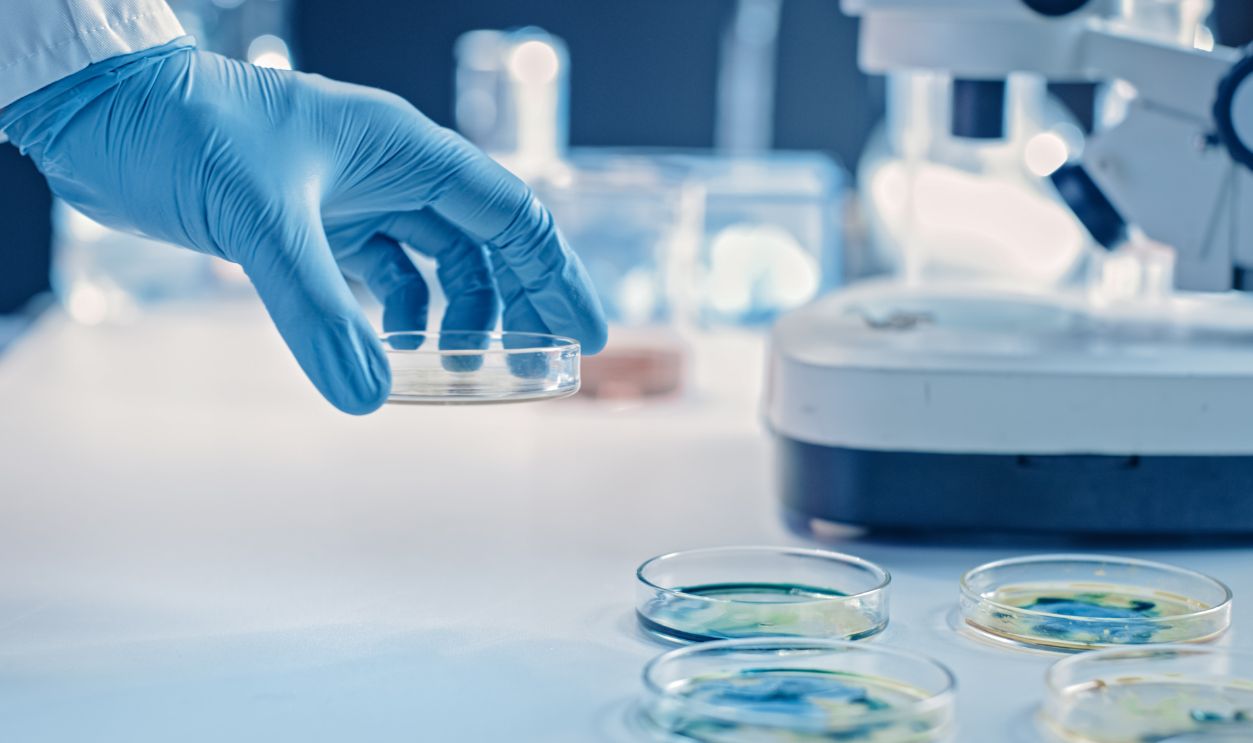
Scientist Works with Petri Dishes with Various Bacteria, Tissue and Blood Samples. Concept of Pharmaceutical Research for Antibiotics, Curing Disease with DNA Enhancing Drugs. Moving Close-up Macro

Science Confronts A Childhood Myth
A second dinosaur image brings back a familiar idea, a quiet hope shaped by years of movie fantasy. Yet the real science behind cloning and ancient DNA shows a tougher reality, where time, decay, and biology shut the door completely.

What Cloning Actually Means
Cloning sounds futuristic, but the idea is to create a new living thing using the exact DNA of another. Nature does it naturally—identical twins are living clones. Scientists replicate this in labs using donor cells, as long as the donor cell's nucleus still carries usable genetic material.
How Modern Cloning Really Works
Scientists clone animals using a method called nuclear transfer. They place a donor nucleus into an empty egg cell and let it develop like a normal embryo. The process is fragile, and success depends on proper reprogramming and early development—not perfect or brand-new DNA.
Rhoda Baer (Photographer), Wikimedia Commons
DNA Is The Core Ingredient
DNA is the instruction manual for building every part of an organism. If even small sections are missing or broken, the body can cause developmental failure. That’s why cloning depends on having the complete genetic blueprint. Adult cells with aged DNA might work, but the success rate is low.
How Jurassic Park Changed Everyone’s Expectations
The movie made cloning dinosaurs look easy: find a mosquito in amber, pull out dinosaur blood, and grow a T rex. Scientists loved the creativity, but the method isn’t real. Amber doesn’t preserve DNA like that, and no dinosaur blood has ever been found.
HarshLight from San Jose, CA, USA, Wikimedia Commons
Early Attempts To Find Ancient DNA (1980s–1990s)
Excitement exploded when researchers thought they found ancient DNA inside amber-preserved insects. The idea felt like Jurassic Park coming true. But later testing revealed the samples were contaminated with modern DNA. No genuine prehistoric DNA was ever confirmed, and the early hopes faded quickly.
Ancient DNA Breaks Down Easily
DNA isn’t a durable material—it falls apart after death. There are many external factors that constantly chip away at it. And even in the best possible conditions, DNA survives only a few million years. After that, it becomes too broken to clone.
DNA’s Expiration Date
In 2012, scientists calculated the decay rate of DNA using extinct birds. They found that after roughly 6.8 million years, a sample would be reduced to unreadable fragments. Dinosaurs died out 66 million years ago, which means their DNA is far past the point of survival.
Why The Amber-And-Mosquito Idea Doesn’t Work
Researchers have been testing insects trapped in amber for decades, hoping to find preserved DNA. Every credible study reached the same conclusion: no ancient DNA survives inside them. Anything detected turned out to be modern contamination, not dinosaur blood or genetic material from the past.
History's most fascinating stories and darkest secrets, delivered to your inbox daily.
Fossils Aren’t Preserved Bodies
A fossil isn’t the original bone. Over millions of years, minerals slowly replace the bone’s material and turn it into rock. The shape remains, but the biology disappears. That means fossils preserve structure, not DNA—so they can’t provide the genetic code needed for cloning.
Frame Stock Footage, Shutterstock
The “Soft Tissue” Surprise In Dinosaur Bones
Some dinosaur fossils contain structures that look like blood vessels or cells. They made headlines, but they’re not actual living tissues. They’re chemically altered remnants with no DNA left inside. They help us study dinosaur biology, but they cannot be used for cloning.
NASA Goddard Space Flight Center from Greenbelt, MD, USA, Wikimedia Commons
We Can’t Rebuild A Dinosaur Genome From Scraps
Cloning needs a full genetic blueprint, not random fragments. Even if we found tiny pieces of dinosaur DNA, we wouldn’t know where they fit or what’s missing. A genome has billions of letters, and guessing the gaps would be impossible. Logically, the final result wouldn’t be a real dinosaur.
Why Modern Birds Can’t Give Us Dinosaur DNA
Birds are descendants of dinosaurs, but 66 million years of evolution have dramatically changed their genes. Their DNA doesn’t contain a hidden “dinosaur code” waiting to be switched back on. Too many mutations and changes make it impossible to reverse-engineer a true prehistoric genome.
Dolly The Sheep Demonstrates The Limits Of Cloning Technology
Dolly proved cloning mammals is possible, but only when scientists have a complete, healthy cell from the original animal. She wasn’t recreated from fragments or fossils. Her success showed the power of cloning, but it also revealed its biggest limit: you must start with good DNA.
Toni Barros from São Paulo, Brasil, Wikimedia Commons
The Oldest DNA Scientists Have Ever Recovered
The oldest confirmed DNA comes from animals preserved in permafrost, like mammoths and ancient horses. Some samples are around one million years old. That sounds ancient, but it’s nowhere near dinosaur age. Beyond a few million years, DNA becomes too damaged to read or restore.
Thomas Quine, Wikimedia Commons
Only Mammoths Fall Within The Reach Of Cloning
Mammoths lived recently and froze in ice, which slowed DNA decay. That gives scientists usable genetic material and a close living relative—the Asian elephant—for potential surrogacy. Dinosaurs, on the other hand, lived in warm climates, fossilized in stone, and left behind zero surviving DNA.
Mauricio Antón, Wikimedia Commons
Surrogate Species Are Essential For Cloning Success
Cloning is beyond DNA; you also need a living species close enough to carry the embryo. Mammals can use related animals as surrogates, but dinosaurs have no living counterparts. Without a compatible body to grow inside, cloning a dinosaur stops before it can even start.
Reassembling Ancient Genomes Exceeds Current Scientific Ability
Even with modern gene-editing tools, it's impossible to rebuild an extinct genome. A genome contains billions of DNA letters arranged with precise timing and regulation. We can edit genes, but creating an entire ancient species blueprint from scratch is impossible today.
De-Extinction Research Focuses Only on Recently Lost Species
Scientists exploring “resurrection biology” focus on creatures like passenger pigeons and Tasmanian tigers because their DNA still exists. These projects rely on preserved tissues and close relatives. Deep-time species like dinosaurs fall completely outside this window, which makes them scientifically unreachable.
Gene Editing Can Reactivate Ancient Traits In Modern Birds
Researchers have used CRISPR to tweak bird embryos to activate features like teeth or longer tails—traits once seen in their dinosaur ancestors. These experiments show how evolution shaped modern birds, but they don’t recreate a dinosaur. They simply reveal hints of features buried in bird biology.
Reverse Engineering Creates Look-Alikes, Not Real Dinosaurs
Altering a bird to resemble a prehistoric creature isn’t the same as bringing a dinosaur back. You can change features, but the underlying DNA remains that of a modern species. The result may look ancient, but it will never behave or function like a true dinosaur.
Dinosaur Traits Can Be Studied Without Recreating The Animal
Scientists can investigate how dinosaurs looked or moved by examining fossil shapes and evolutionary links to birds. Even the bone growth patterns hint at the same thing. These methods reveal feather structures and body mechanics. They help us understand dinosaurs deeply—without needing DNA or attempting to resurrect them.
Ancient Proteins Offer Clues, But Cannot Restore A Species
A few fossils contain tiny traces of ancient proteins, which help researchers study dinosaur muscle structure or evolutionary relationships. But proteins are not DNA. They can’t be used to rebuild a genome, clone an animal, or recreate anything that's even remotely like a living dinosaur.
Virtual Reconstruction Allows Accurate Dinosaur Models
Advanced scanning and computer simulations let scientists recreate how dinosaurs behaved as we saw in the movies. These digital models are built from real fossil measurements and physics. They create vivid, lifelike reconstructions, which offer insight into extinct species without needing a single strand of surviving DNA.
Frame Stock Footage, Shutterstock
The Limits Of Science Keep Jurassic Park In Fiction
Now that we know that cloning requires intact DNA and a compatible surrogate. Dinosaurs offer none of these. Fossils replaced their biology, time destroyed their genes, and no living species can host them. These barriers keep Jurassic Park firmly in the realm of imagination.
Thank You (23 Millions+) views from Los Angeles, USA, Wikimedia Commons
Even Ideal Preservation Cannot Save Dinosaur DNA
Even perfect conditions—deep freeze, dry caves, complete darkness—cannot preserve DNA for tens of millions of years. Chemical bonds continue breaking until the genetic code becomes unreadable. Dinosaur DNA simply does not survive long enough to be cloned or reconstructed in any realistic scenario.